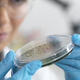

V človeških tkivih, še posebej v možganih in jetrih, se je v zadnjih osmih letih bistveno povečala koncentracija mikro- in nanoplastike, kažejo izsledki študije, objavljene v reviji Nature Medicine. S …
Regional · 10M

Znanstveniki so odkrili zaskrbljujoče ravni mikroplastike v možganih ljudi z demenco 🧠 Raziskovalci so analizirali vzorce tkiv 24 oseb , umrlih leta 2024 , in jih primerjali z 28 vzorci …
Metropolitan.si · 10M

Študija: V človeških možganih in jetrih vse več plastičnih delcev.
Mariborinfo · 10M
Študija pokazala bistveno višje ravni plastičnih nano- in mikrodelcev v jetrih in možganih ljudi, ki so umrli leta 2024, v primerjavi s tistimi, ki so jih preučevali leta 2016. V …
Žurnal24 · 10M

Prisotnost plastike v možganih je bila do 30-krat višja kot v drugih organih, so ugotovili ameriški raziskovalci.
Svet24 · 10M

V človeških tkivih, še posebej v možganih in jetrih, se je v zadnjih osmih letih bistveno povečala koncentracija mikro- in nanoplastike, kažejo izsledki študije, objavljene v reviji Nature Medicine. S …
24ur · 10M